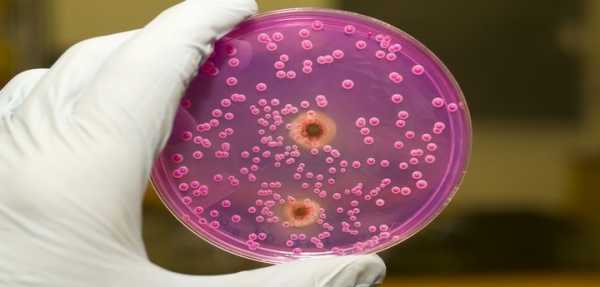

Какие антибиотики принимать при фолликулярной ангине
Врачи чаще всего назначают антибиотики при фолликулярной ангине. Как показывает медицинская практика, в 80% случаев возбудителем заболевания является бета-гемолитический стрептококк группы А (БГСА). Гораздо реже тонзиллит вызывают стрептококки групп С и G, другие виды бактерий, вирусы, анаэробы, спирохеты, микоплазмы и хламидии. Но даже если фолликулярная ангина имеет небактериальное происхождение, в процессе ее развития часто присоединяется бактериальная инфекция. Патогенные микроорганизмы повреждают систему местной защиты и способствуют колонизации бактерий на слизистых оболочках верхних и нижних дыхательных путей.
Важность антибиотиков

При диагностировании фолликулярной ангины бактериальной этиологии в обязательном порядке назначается антибиотикотерапия. Особенно важно применять антибиотики, если возбудителем заболевания является БГСА. Данная ангина опасна осложнениями. Она способна спровоцировать перитонзиллярный абсцесс, ревматическую лихорадку, бактериальный эндокардит (воспаление внутренней оболочки сердца), гломерулонефрит (заболевание почек), токсический шок, септицемию (заражение крови).
Для определения природы происхождения тонзиллита может потребоваться от 3 до 7 дней. Применяемая в последнее время экспресс-диагностика БГСА позволяет выявить возбудителя заболевания во время осмотра больного в течение 10 минут. Однако в 14% случаев фиксируется ложноотрицательный результат. Поэтому при отрицательном результате анализа, согласно санитарным правилам «Профилактика стрептококковой (группы А) инфекции», проводится культуральное исследование.

Пока будут готовы результаты анализов, у больного могут развиться тяжелые осложнения. Поэтому при наличии эпидемиологических и клинических данных, указывающих на стрептококковую природу фолликулярной ангины, антибактериальное лечение назначается до получения результатов бактериологического исследования.
Целью антибактериальной терапии острой формы тонзиллита является уничтожение возбудителей заболевания. Чем раньше будут нейтрализованы патогенные микроорганизмы, тем меньше вероятность развития ранних и поздних осложнений.
Как подбирают препараты для лечения

Бета-гемолитический стрептококк группы А отличается высокой чувствительностью к пенициллинам и цефалоспоринам. Бета-лактамы (подгруппы пенициллинов и цефалоспоринов) являются единственным классом антибактериальных препаратов, к которым у БГСА сохраняется высокая восприимчивость. Для лечения заболевания используются макролиды. Однако в 13-17% к макролидам развивается резистентность. Чаще всего наблюдается М-фенотип устойчивости, при котором обнаруживается невосприимчивость к макролидам и чувствительность к линкозамидам. Линкозамиды тоже используются для лечения фолликулярной ангины. Но к ним у патогенной микрофлоры быстро развивается устойчивость.
В более чем 60% случаев БГСА не восприимчив к тетрациклинам и сульфаниламидам. Даже если обнаружена чувствительность к препаратам, они не обеспечивают полного уничтожения патогенных микроорганизмов. Поэтому их не используют для лечения фолликулярной ангины.

Поскольку тонзиллит является самокупирующимся заболеванием и может заканчиваться выздоровлением без лечения, многие больные ограничиваются препаратами местного действия (полоскания, ингаляции, спреи). Подобный подход может привести к печальным последствиям. Препараты для наружного применения могут использоваться только в комбинации с системными лекарственными средствами.
При назначении препаратов руководствуются принципом рациональной антибактериальной терапии. Подбирается лекарственное средство, которое обеспечивает максимально быстрое клиническое и бактериальное выздоровление. Спектр его действия должен соответствовать вероятному возбудителю инфекции. Препарат должен преодолевать вероятные механизмы устойчивости патогенных микроорганизмов и создавать в очаге поражения максимальную концентрацию. При выборе антибиотика уделяется внимание лекарственной форме, удобству применения и низкой вероятности побочных реакций.
Применение пенициллинов

Несмотря на то, что пенициллин является первым открытым видом антибиотиков, он до сих пор является самым эффективным средством для лечения фолликулярной ангины. Пенициллины успешно уничтожают стрептококк, стафилококк и синегнойную палочку. В отличие от многих других лекарственных препаратов, они не опасны для человека. Клетки пенициллиновых грибков существенно отличаются от человеческих клеток, поэтому не оказывают на них негативного воздействия. Антибиотики группы пенициллинов разрешены для применения во время беременности и кормления грудью. Они не влияют на развитие плода.
Пенициллины отличаются хорошими показателями фармакокинетики. Они быстро всасываются в желудке и медленно расщепляются ферментами. В редких случаях препараты могут вызвать расстройства пищеварения.
В последнее время отмечается увеличение резистентности патогенных микроорганизмов к пенициллинам. Частота неудач пенициллинотерапии фолликулярной ангины составляет 25-30%. Некоторые штаммы бактерий научились вырабатывать фермент бета-лактамазу, который разрушает бета-лактамное кольцо антибиотиков. Бета-лактамаза может продуцироваться микроорганизмами копатогенами (организмы условно-патогенной микрофлоры), присутствующими в глубоких тканях миндалин.
С целью предотвращения разрушения бета-лактамного кольца действующего вещества в препараты добавляют специальное соединение, которое подавляет выработку бета-лактамазы. К таким соединениям относятся клавулановая кислота, тазобактам, сульбактам. Препараты, содержащие пенициллин и ингибитор бета-лактамазы, называют ингибиторзащищенными пенициллинами.
Препараты группы пенициллинов

При фолликулярной ангине взрослому человеку назначаются полусинтетические антибиотики Аминопенициллины (Ампициллин и Амоксициллин) и природный антибиотик Феноксиметилпенициллин. Как и другие бета-лактамы, Аминопенициллины и Феноксиметилпенициллин оказывают бактерицидный эффект за счет угнетения синтеза клеточной стенки бактерий. Среди природных антибиотиков у Феноксиметилпенициллина самая высокая минимальная подавляющая концентрация.
Чаще всего используется при фолликулярной ангине Амоксициллин (Флемоксин Солютаб, Оспамокс, Апо-Амокси, Амоксисар, Амосин). По своей антистрептококковой активности Амоксициллин не уступает Ампициллину и Феноксиметилпенициллину. Однако он превосходит их по своим фармакокинетическим характеристикам. Его биодоступность почти в 2 раза выше, чем у Ампициллина и Феноксиметилпенициллина. Она достигает 80% (в форме Солютаб — 95%). Амоксициллин меньше связывается с белками (17%), особенно по сравнению с Феноксиметилпенициллином (80%). Препарат быстро всасывается и проникает в большинство жидкостей и тканей организма. В отличие от других препаратов Амоксициллин можно принимать вне зависимости от приема пищи. Он выводится преимущественно почками (50-70%) и печенью (10-20%).

При наличии хронического тонзиллита, вызванного бета-гемолитическим стрептококком группы А вероятность колонизации очага инфекции патогенными микроорганизмами, вырабатывающими бета-лактамазу, увеличивается. В таких случаях целесообразно осуществлять лечение ингибиторзащищенными пенициллинами. К ним относятся препараты Амиксициллин + Клавулановая кислота (Аугментин, Амоксиклав, Флемоклав-Солютаб) и Ампициллин + Сульбактам (Амписида, Сультасина). Их антимикробный спектр охватывает ряд грамоотрицательных бактерий и анаэробов, которые синтезируют хромосомные бета-лактамазы класса А. Ингибиторзащищенные пенициллины назначают и в случаях, когда пенициллинотерапия острой формы фолликулярной ангины оказалась безуспешной.
Применение цефалоспоринов

Цефалоспорины назначают в тех случаях, когда обнаружена резистентность болезнетворных микроорганизмов к препаратам группы пенициллинов при наличии восприимчивости к бета-лактамам. Терапия цефалоспоринами используется, если лечение пенициллинами не дало желаемого результата, кроме того, при наличии аллергической реакции у больного на пенициллин. Благодаря высокой эффективности и низкой токсичности цефалоспорины занимают одно из первых мест по частоте клинического использования при фолликулярной ангине.
Бактерицидное действие цефалоспоринов связано с нарушением образования клеточной стенки бактерий, как и у пенициллинов. Структурное сходство бета-лактамов определяет не только одинаковый механизм действия, но и перекрестную аллергию у некоторых больных.
Существует 4 поколения цефалоспоринов. Каждое новое поколение препаратов имеет более широкий спектр действия. У последних поколений цефалоспоринов антимикробная активность к грамотрицательным бактериям повышена, а активность в отношении грамположительных микроорганизмов снижена.
Цефалоспорины реже других антибиотиков вызывают гепатотоксические реакции.
Препараты группы цефалоспоринов

При фолликулярной ангине нередко назначается цефалоспорин I поколения Цефадроксил. Он демонстрирует высокую эффективность при лечении заболевания, вызванного БГСА. Лекарство хорошо переносится и редко вызывает побочные реакции. Как и другие цефалоспорины I поколения, Цефадроксил устойчив к действию стафилококковых бета-лактамаз. Однако некоторые штаммы, отличающиеся гиперпродуктивностью фермента, могут проявлять низкую чувствительность к Цефадроксилу.
Лекарственный препарат быстро всасывается при приеме внутрь. Одновременный прием пищи практически не влияет на его усвоение. Цефадроксил слабо связывается с белками (15-20%) и медленно выводится. Клинически значимые концентрации возникают преимущественно в миндалинах. Практически 90% препарата выводится с мочой.

При фолликулярной ангине может быть назначен цефалоспорин II поколения Цефуроксим. Лекарственный препарат отличается высокой активностью по отношению к стрептококкам и стафилококкам. Он стабилен в присутствии большинства бета-лактамаз. Цефуроксим действует на штаммы бактерий, которые имеют устойчивость к Ампициллину и Амоксициллину. Препарат характеризуется высокой связываемостью с белками плазмы (50%). Его биодоступность повышается после приема пищи. 50% дозы выводится с мочой в течение 12 часов.
Цефалоспорины III поколения характеризуются высоким уровнем активности по отношению к стрептококкам, в том числе к БГСА. При фолликулярной ангине назначают базовый препарат группы цефалоспоринов III поколения Цефтриаксон. Он характеризуется устойчивостью к действию большинства бета-лактамаз. Препарат изготавливается в виде инъекций. Его используют, когда диагностируют тяжелую форму тонзиллита. Биодоступность лекарства достигает 100%, он сохраняет бактерицидную активность на протяжении 24 часов. Цефтриаксон имеет высокую обратимую связываемость с белками (до 95%). 50-60% лекарственного средства выводится у взрослых с мочой, а 40-50% — с желчью.

В качестве альтернативы инъекциям Цефтриаксона может быть назначен пероральный цефалоспорин III поколения Цефиксим. Его биодоступность составляет 40-50% и не зависит от приема пищи. С белками плазмы связывается около 65% препарата. Он выводится в неизменном виде с мочой в течение 24 часов (50-55%).
Применение макролидов

Хотя БГСА считают внеклеточными микроорганизмами, проведенные исследования подтвердили их способность проникать в эпителиальные клетки органов дыхательной системы человека, где они оказываются неуязвимыми для антибиотиков. Бета-лактамы обладают слабой способностью проникать через клеточную оболочку. Поэтому они неэффективны в отношении внутриклеточных микроорганизмов (хламидии, микоплазмы).
Особенно актуальна эта проблема для людей с хронической формой фолликулярной ангины. При хроническом воспалении, сопровождающемся неполным фагоцитозом (поглощение фагоцитами бактерий), микроорганизмы размножаются в фагоцитарных клетках.
Еще одной проблемой при хроническом тонзиллите является образование биопленок. Полисахаридные структуры, формирующие матрикс биопленок, эффективно защищают патогенные микроорганизмы от воздействия лекарственных препаратов.

Способностью преодолевать клеточную оболочку и просачиваться в бактериальную биопленку обладают макролиды. Они также оказывают иммуномодулирующее и противовоспалительное действие.
Макролиды нарушают синтез белка микроорганизмов. Основное терапевтическое значение имеет высокая активность макролидов в отношении стрептококков и стафилококков, внутриклеточных возбудителей заболеваний.
В зависимости от количества атомов углерода макролиды бывают 14-, 15- и 16-членными. Последние из них имеют высокую активность в отношении пиогенных стрептококков, невосприимчивых к другим видам макролидов.
Кроме высокой антистрептококковой активности, макролиды обладают свойством создавать высокую тканевую концентрацию в области поражения. Лекарственные средства хорошо переносятся. Их несомненным достоинством является короткий курс лечения.
Макролиды гораздо реже бета-лактамов вызывают аллергическую реакцию.
Препараты группы макролидов

Среди лекарств группы макролидов максимально повышает иммунный ответ Кларитромицин (Клацид). Он увеличивает активность макрофагов и нейтрофилов, кроме того, активизирует Т-киллеры. Это важно при лечении заболевания, вызванного смешанной инфекцией (вирусами и бактериями).
Преимуществом Кларитромицина является способность разрушать матрикс биопленки. Он повреждает ее структуру и не дает ей функционировать. Лекарственное средство делает ее проницаемой не только для себя, но и для других антибиотиков. Кларитромицин обладает свойством проникать в ткани органов дыхательной системы и концентрироваться в них. Уровень действующего вещества в органах превышает в 2-6 раз концентрацию в плазме. Значительное количество препарата концентрируется в тканях небных миндалин. Такая особенность Кларитромицина позволяет добиться терапевтического эффекта даже при наличии устойчивости патогенных микроорганизмов к препарату.

Достоинством Кларитромицина является его свойство образовывать в организме активный метаболит (продукт распада) — 14-гидрокси-кларитромицин. Это вещество имеет антибактериальное свойство и усиливает действие Кларитромицина в отношении некоторых стафилококков и стрептококков.
Лекарственное средство оказывает постантибиотическое действие. Оно подавляет рост колоний патогенных микроорганизмов даже тогда, когда уже не присутствует в среде их обитания. Кларитромицин быстро всасывается. Одновременный прием пищи замедляет усвоение, но не снижает биодоступность препарата. Связь с белками может превышать 90%. Препарат выводится почками (38-46%) и с каловыми массами (30-40%). Он редко вызывает побочные реакции. Они проявляются слабо и носят кратковременный характер.
При фолликулярной ангине может быть назначен другой препарат из группы макролидов — Азитромицин. Курс лечения препаратом обычно не превышает 3 дней. Благодаря устойчивости в кислой среде Азитромицин быстро всасывается из желудочно-кишечного тракта. Его биодоступность составляет 37%. Высокая эффективность Азитромицина обусловлена его способностью проникать в очаг поражения с помощью фагоцитов. Препарат высвобождается во время фагоцитоза и оказывает антибактериальное действие. Медленное выведение лекарственного вещества вызвано его низкой связываемостью с белками.
Применение линкозамидов
Линкозамиды оказывают преимущественно бактериостатическое действие. Они подавляют у возбудителей заболевания выработку белка. При высоких концентрациях в отношении высокочувствительных штаммов могут вызывать гибель микроорганизмов. Препараты группы линкозамидов назначаются только в том случае, когда патогенные бактерии имеют низкую чувствительность к бета-лактамам и макролидам. Линкозамиды также могут быть рекомендованы, если лечение этими препаратами не привело к выздоровлению.

К группе линкозамидов относятся природный антибиотик Линкомицин и его полусинтетический аналог Клиндамицин. Линкомицин (Медоглицин, Нелорен, Цилимицин, КМП-Линкомицин, Линосин, Линкомицин-Акос) быстро всасывается из пищеварительного тракта. Однако его биодоступность невысока. При приеме средства натощак она составляет 30%, а после приема пищи — не более 5%. Связывание Линкомицина с белками плазмы достигает 75%. Препарат хорошо проникает в органы и жидкости. Он медленно выводится из организма.

Клиндамицин (Далацин, Зеркалин, Клиндатоп, Клиндес, Клиндовит) имеет более высокую антибактериальную активность по сравнению с Линкомицином. Исключение составляют только линкомицинорезистентные штаммы. Он также быстро всасывается из желудочно-кишечного тракта. Его биодоступность достигает 90%. Прием пищи замедляет всасывание, но не снижает биодоступность лекарства. Клиндамицин имеет высокое связывание с белками (до 95%). Он быстро проникает в ткани организма, в том числе и в миндалины. В отличие от Линкомицина Клиндамицин быстро выводится из организма. Иногда наблюдается перекрестная резистентность Клиндамицина и макролидов.
Лечение антибиотиками нужно осуществлять в строгом соответствии с рекомендациями лечащего доктора. Нельзя изменять дозировки препаратов и сокращать курс лечения, даже если состояние больного значительно улучшилось и он чувствует себя здоровым. Самовольное сокращение курса и уменьшение дозировок не позволит добиться терапевтического эффекта. Выжившие микроорганизмы могут вызвать обострение заболевания или осложнение. Они приобретут устойчивость к лекарственному средству, поэтому лечить патологию будет труднее. Превышение дозировок может вызвать почечную и печеночную недостаточность.
gorlonebolit.ru
Антибиотики при фолликулярной ангине у взрослых и детей
Антибиотики при фолликулярной ангине – это самый оптимальный способ лечения данного заболевания. Они используются не только для улучшения состояния всего организма, снятия симптомов, последствий болезни, но и в профилактических целях.
Фолликулярная ангина – это острое инфекционное заболевание, которое поражает миндалины. Как правило, возбудителем инфекции является стрептококк – вирусная бактерия, попадающая в человеческий организм через пищеварительный путь, а поселяется она в горле и полости рта. Как правило, чаще всего данному заболеванию подвержены именно дети. Поэтому необходимо детально рассмотреть вопрос о том, как лечить фолликулярную ангину без применения антибиотиков, так как они только вредят не сформировавшемуся организму.
Симптомы

Характерные симптомы фолликулярной ангины:
- Начало заболевания характерно внезапным повышением температуры.
- Неприятные ощущения в горле и полости рта.
- Образование воспалительных процессов на миндалинах.
- Белый налет в горле.
- Увеличение лимфатических узлов.
- Общее недомогание, которое сопровождается слабостью, раздражительностью и рвотными позывами.
Лечение антибиотиками
Существует множество медикаментов для лечения ангины, но все они разделяются на две группы:
- Цефалоспорины — по безопасности и эффективности они практически идентичны ниже упомянутым пенициллинам, но отличаются более ярко выраженным действием. В числе антибиотиков при ангине — Цефадроксил, Дурацеф, Супракс, Азаран, Апо-Цефалекс и другие;
- Макролиды, среди которых находится один из наиболее часто применяемых при ангине антибиотиков — Эритромицин. К этой же группе относятся Азитромицин, Джозамицин, Спиромицин и другие, из препаратов — Сумамед, Азитро-Сандоз, Хемомицин.
Также следует выделить такие группы лекарственных препаратов, как линкозамиды — клиндамицин и линкомицин, которые назначаются довольно редко ввиду того, что при фолликулярной ангине они способны вызвать нежелательные побочные эффекты.
Лечение без антибиотиков

Многим известно, что антибиотики очень вредят здоровью, а особенно детскому организму, поэтому специалисты рекомендуют совмещать традиционное и народное лечение. Из способов народного лечения следует выделить:
- Обильное питье – помогает выводить из организма шлаки и снимает температуру.
- Так как, бактерия чаще всего живет в полости рта и носа, рекомендуется полоскание спиртовым раствором хлорофиллипта, разбавленным водой. Также можно полоскать антисептиком (фурацилин).
- Хороший эффект дает закапывание косточковым маслом носа перед сном: в каждую ноздрю по одной полной пипетке, таким образом, смазывается горло, предотвращается першение.
- Ларипронт хорошо подходи для дезинфекции полости рта и горла.
- Также следует помнить, что некоторым пациентам из-за индивидуальной непереносимости антибиотики противопоказаны, поэтому им назначается лечение аналогичными антибактериальными веществами.
Нельзя заменить лечение полностью средствами народной медицины, так как этим, вы можете только навредить своему организму.
Лечение ангины у детей
Лечение детей происходит по аналогичной схеме, как у взрослых, но с одним условием – детям назначается больше стимулирующих и вспомогательных препаратов, (витамины) чтобы организм легче переносил период заболевания. Из щадящих медикаментов следует выделить:
- Амоксициллин Сандоз – препарат, применяющийся для лечения фолликулярной ангины у детей и профилактики заболевания. Пенициллин обладает хорошими фармакокинетическими и фармакологическими показателями. Активнодействующий элемент – пенициллин, который характерен малыми побочными эффектами и противопоказаниями.
- Супракс – лекарственная микстура, сделанная на основе активнодействующего вещества – цефалоспорин, который, как и пенициллин обладает малыми побочными эффектами, поэтому легко воспринимается организмом. Микстура назначается для подавления первых симптомов фолликулярной ангины.
Лечение кормящих мам
Если у кормящей мамы резко поднялась температура, ухудшилось самочувствие, то это еще не повод прекращать грудное вскармливание, так как молоко вырабатывается несмотря на все проблемы со здоровьем матери. При подтверждении диагноза, стоит начать принимать антибиотики, но кормление грудью можно продолжать, так как они не влияют на него. Из препаратов, которые подходят беременным следует выделить:
- Феноксиметилпенициллин и Ампициллин – лекарственные медикаменты, которые идеально подходят мамам, так как в их основе лежит уже знакомый пенициллин.
- Азитро Сандоз – макролид, назначающийся при фолликулярной ангине, который имеет антибактериальное свойство. Но, следует выделить главный минус этого препарата – длительный прием может вызвать расстройство кишечно-желудочного тракта. Поэтому настоятельно рекомендуется его чередовать с пенициллиносодержащими медикаментами.
Фолликулярная ангина – это довольно серьёзное заболевание, а ее лечение происходит стандартными противовирусными, антибактериальными антибиотиками, которые хорошо зарекомендовали себя за долгое время. Например, это может быть: Пенициллины, Эритромицин, Цефалоспорины. Антибиотики назначает врач, который учитывает все особенности организма пациента и динамику развития заболевания. Также следует заметить, что лечение данного вида ангины не особо отличается от гнойной, катаральной либо лакунарной ангины.
lorvdele.ru
Антибиотики при фолликулярной ангине у взрослых |

Лечение фолликулярной ангины проводится такими же антибиотиками, какие используются и при борьбе с другими формами болезни. В первую очередь производится выбор из препаратов на основе пенициллинов, если они по каким-то причинам не подходят — выбираются антибиотики других групп:
- Цефалоспорины — по безопасности и эффективности они практически идентичны пенициллинам. В числе этих препаратов — Цефадроксил, Дурацеф, Супракс, Азаран, Апо-Цефалекс и другие;
- Макролиды, среди которых находится один из наиболее часто применяемых при ангине антибиотиков — эритромицин. К этой же группе относятся азитромицин, джозамицин, спиромицин и другие, из препаратов — Сумамед, Азитро-Сандоз, Хемомицин.

Хемомицин — один из препаратов на основе азитромицина
Линкозамиды — клиндамицин и линкомицин — назначаются редко. Эти антибиотики при фолликулярной ангине могут вызывать серьезные побочные эффекты, и потому их применение оправдано лишь в тех случаях, когда остальные препараты по тем или иным причинам назначать нельзя.
Для назначения действительно эффективного антибиотика при фолликулярной ангине врач должен знать:
- Какими бактериями вызвана ангина;
- Какие антибиотики больной принимал ранее, имелись ли у него аллергические реакции;
- Болел ли пациент ангинами в прошлом.
Как правило, тип возбудителя врач обычно не знает — выявление его требует не менее 3-4 дней, за которые ангину уже можно подавить антибиотиками широкого спектра действия. Поэтому выбирая, какой антибиотик надо назначить при фолликулярной ангине в конкретном случае, врач обычно учитывает вероятность аллергии и прописывает наиболее эффективный препарат, который будет активен и против стрептококка, и против стафилококка. Очевидно, что назначать себе антибиотик самостоятельно, без врача и учета собственной гиперчувствительности, опасно.

Стафилококк вызывает ангину реже, чем стрептококк, но он же обычно более устойчив к антибиотиками
Отзыв
«Один раз у нас на двоих детей была ангина. У Маши в четыре года фолликулярная. Врач прописал Сумамед, такой порошок с ложкой и мерным шприцом. Все удобно, применять легко, но больше всего меня удивил результат. Вот представьте: у ребенка ангина, воспаленное горло, гнойники на миндалинах, он плачет, температура. Мне реально страшно. Три раза в день пьет раствор порошка, на ут
lor-prostuda.ru
Как действуют антибиотики при фолликулярной ангине у взрослых?
Для многих слово ангина хорошо знакомо, и чаще всего, с детских лет. Именно в этот период много обращений к врачу за помощью, и, если она была несвоевременно оказана, могут быть осложнения. Не зная точного диагноза, пациенты принимают антибиотики при фолликулярной ангине, или, если это ангина другого вида, но этого не стоит делать без консультации врача.

Ангина, или тонзиллит, заболевание, которое протекает в острой форме, имеет инфекционную природу и возбудителями могут быть как бактерии, так и вирусы. Заражение происходит, как правило, через носоглотку, и первой преградой на пути инфекции стоят лимфатические узлы. В переводе с латыни слово ангина означает сдавливать, сжимать. Но удушьем страдают при воспалении горла очень редко, только одна из форм может вызвать отек гортани.
Основной ошибкой является решение самостоятельно прописать себе антибиотики, считают, что это поможет быстро справиться с болезнью.
Другие напротив, стремятся избежать приема, считая их вредными и опасными. И то и другое мнение неверно. То, какой из антибиотиков прописать в каждом конкретном случае, решает только врач. Он основывается не только на симптомах болезни, но и оценивает общее состояние пациента, его анализы, насколько часто он болеет. Только все эти факторы в комплексе могут показать верную картину, и никакие советы и статьи в интернете не смогут помочь больному со стопроцентной гарантией. Обращение к врачу обязательное условие для проведения эффективного лечения.
Группа риска
Если учитывать данные, то можно отметить, что чаще всего болеют дети, и молодые люди. После 40 лет ангина встречается крайне редко, или протекает в легкой форме. Большой процент заболевших отмечают в крупных городах, так как скопление большого количества людей позволяет инфекции распространяться с огромной скоростью.

Отдельно стоит группа людей, у которых есть патологии, индивидуальные отличия, травмы и различные нарушения. На вредных производствах проблема стоит довольно остро, так как неблагоприятные условия способны наносить вред здоровью, особенно, если работник занимается этим трудом долгие годы. Плохо влияют загазованность, запыленность воздуха, резкие перепады температурного режима.
Любой человек при экстремальных условиях, частых переохлаждениях может заболеть. Могут стать причиной заражения такие факторы как:
- стресс;
- не полноценное питание;
- общее ослабление организма;
- снижение иммунитета;
- недостаток витаминов;

Употребление в летний период холодных напитков, большое скопление людей на водоемах, резкие перепады температуры при использовании климат контроля, способны уложить на несколько дней человека в постель с острой болью в горле. Не только зимой наблюдают вспышки заболевания, так что стоит относиться к этой проблеме внимательно, чтобы не испортить себе отдых.
Клиническая картина
Любая инфекция имеет инкубационный период. Коварная болезнь не сразу заявляет о своем присутствии, а испытывает нас на прочность, нашу иммунную систему. Найдя слабое звено, вирус активизируется, через 2 дня появляются первые признаки. Длится этот период около суток, появляется ломота в суставах и мышцах, человека начинает лихорадить, резко подскакивает температура до критических показателей. Болезненные ощущения в глотке появляются в зависимости от формы ангины, и не всегда в первый день. Может быть головная боль, отказ от еды, слабость. Длится болезнь около недели, и при грамотном подходе к лечению, восстановление наступает довольно быстро.
Виды
Существует четыре вида:
- Вирусная ангина возникает в результате воздействия на организм вирусов различной природы. Их насчитывается несколько, и каждый по-своему может повлиять на клиническую картину болезни;
- Бактериальная. Такие бактерии как стрептококк, стафилококк, пневмококк, менингококк, брюшной тиф, сибирская язва выступают главными виновниками фолликулярной ангины;
- Грибковая ангина. Вызвана грибками, имеет схожие симптомы с бактериальной;
- Самый редкий вид, это ангина Симановского-Плаута-Венсена. В данном виде выступает симбиоз разных инфекций. Задействована веретенообразная палочка и спирохета полости рта.

Заразиться пациент может не только всем известным, воздушно-капельным путем, но и в результате попадания инфекции изнутри. Причиной могут стать:
- гайморит;
- кариес;
- хроническая форма воспаления миндалин;
Признаки
Так как оперативность в лечении ангины крайне важна, то зная первые признаки, которые предшествуют активному всплеску заболевания, можно существенно сократить сроки болезни и ее тяжесть. Особенно важно это для тех, кто страдает от рецидива по нескольку раз в год. Ангина может характеризоваться такими проявлениями как:
- Общая интоксикация организма. Появляется ломота во всем теле, головная боль и слабость;
- Повышение температуры тела до максимальных значений. Ее о показания зависят от состояния глотки, и чем они выше, тем меньше воспалено горло;
- Лимфаденит. Лимфатическая система отзывается на болезнь, узлы увеличиваются в определенных зонах;
- Болезненные ощущения в области горла и шеи порой могут быть так сильны, что затрудняют не только прием пищи, а даже поворот головы. Все зависит от тяжести болезни и ее формы;
- В составе крови происходят определенные изменения, повышается СОЭ.
- Сердечно-сосудистая система дает сбой. Учащается сердцебиение, появляются признаки сердечной недостаточности, может быть миокардит;
- В некоторых случаях наблюдается увеличение почек и печени;
- Если это беременная женщина, могут наблюдаться патологии плода;
Когда лимфоузлы воспалены, то появляется отечность и краснота на миндалинах при катаральной ангине.
Фолликулярная, дает картину иную, на небе образуются везикулы беловатого цвета, плотно усыпающие практически всю ротовую полость.
Формы
Фолликулярная ангина визуально определяется легко, так как на всей поверхности видны включения желтоватого цвета, при надавливании вытекает гнойная жидкость. Это одна из острых форм, воспалительные процессы проходят болезненно, общее состояние средней тяжести. Затягивание лечебного процесса может приводить к тяжелым последствиям. Миндалины расположены так, что в непосредственной близости проходят кровеносные магистрали, отвечающие за весь организм, есть вероятность возникновения сепсиса. Также велик шанс возникновения менингита, еще болезнь влияет на суставы, развивается артрит.
Катаральная характеризуется как самая легкая по форме ангина, поражается только поверхностная оболочка слизистой, возникает небольшая отечность миндалин и могут воспалиться лимфоузлы. Как дополнительные симптомы можно отметить сухость, першение в горле, незначительная боль при сглатывании. Поднимается невысокая температура, в пределах 37,5 градусов.
При лакунарной ангине могут наблюдаться схожие симптомы с фолликулярной, но есть и существенные отличия.
Лимфатические узлы увеличиваются настолько, что вызывают болезненные ощущения у пациента, отекает и «язычок» в центре носоглотки, нарушается слюноотделение, сглатывать слюну больно, и она вытекает, особенно сильно это касается маленьких детей.

Фибринозная ангина возникает как самостоятельное заболевание, так и последствие лакунарной.
Флегмонозная, поражает только одну сторону горла, отек распространяется на шею, сильно увеличиваются лимфатические узлы.
Некторическая ангина довольно редкая форма, при которой миндалины отмирают.
Герпетическая форма вызванная вирусами, на миндалинах нет гнойных включений и налета.
Некоторые формы объединяет наличие гнойных пробок на миндалинах, как правило, такие симптомы бывают при фолликулярной и лакунарной ангине, ее называют гнойной. Именно такая форма самая заразная, и часто вся семья страдает от этого заболевания.
Симптомы фолликулярной формы
Так как симптомы многих форм схожи, выяснить, какие у них отличия, наша задача.
Как правило, болезнь развивается стремительно, появляется резкая боль в горле, повышается температура тела. Даже сглатывание слюны доставляет острую боль, а лимфатические узлы в области шеи существенно увеличиваются. Боль может распространяться на органы, расположенные в непосредственной близости. Поступали жалобы на боль в ухе и височной кости. На миндалинах образуются гнойные мешки желтоватого цвета, при этом происходит общая интоксикация организма. Появляется сильная головная боль и боль в мышцах, человек становится сонливым, вялым, суставы ноют, появляется озноб. Анализ крови показывает высокий процент лейкоцитов.
Для маленьких, не окрепших пациентов ангина опасна осложнениями, менингитом, может в тяжелых случаях наблюдаться потеря сознания, расстройство стула, рвота.
Причины
Основными виновниками возникновения заболевания являются стрептококки, стафилококки, пневмококки, именно они отвечают за 80% всех случаев гнойной ангины. Иногда происходит объединение двух кокков, и тогда на их долю приходятся остальные 20% случаев. Передается фолликулярная ангина бытовым путем, и это позволяет ей находить новые жертвы довольно быстро. Детский сад, школа, да и любое общественное место может стать объектом, где заразился ребенок, или взрослый. При первых же признаках необходимо оградить всех членов семьи от больного, тщательно проводить дезинфекцию помещения. Бактерии довольно живучи, и даже при очевидном улучшении состояния, могут находиться в активной фазе.
Лечение
Главное, после определения вида ангины, и ее типа, чтобы терапия носила комплексный характер. Нельзя ограничиться только приемом лекарственных препаратов, или применять народные средства. Эффективность лечения напрямую зависит от того, как будут выполняться назначения врача.

Так как чаще всего болезнь носит острую форму, то обязательно назначают курс антибиотиков. Это могут быть препараты, которые принимают орально, но скорее назначают инъекции, так как они более эффективны. Проводится и местное симптоматичное лечение в сочетании с сульфаниламидными и антигистаминными препаратами.
Терапия при гнойной ангине направлена на достижение следующих показателей:
- подавление патогенной среды;
- снижение болевых ощущений в глотке;
- нейтрализация токсинов в организме;
Для лечения фолликулярной ангины лучше всего подходят антибиотики пенициллиновой группы. Принцип действия таков, что он подавляет синтез пиптедогликана. Рекомендуют применение таких препаратов как:
- Бензилпенициллин;
- Амоксициллин;
- Ампициллин;
- Бициллин;
Существует и другая группа антибиотиков из макролидов, Азитромицин, Эритромицин, из цефалоспоринов Цифалексин, Цефазолин.
Врачи настойчиво предупреждают о том, что прогревание миндалин не может быть полезным, так как это приводит к ухудшению состояния пациента.
Это связано с тем, что тепло создает благоприятную среду для размножения бактерий, и ошибочное мнение что тепловые процедуры помогают справиться с инфекцией могут серьезно навредить ослабленному болезнью организму. Тепловые компрессы допустимы только в области лимфатических узлов, и исключительно спиртовые. Нельзя предпринимать никаких самовольных действий, пользоваться непроверенными народными рецептами.
Нельзя полагаться только на действие антибиотиков и не уделять внимание симптоматическому лечению. Конечно, проще выпить несколько таблеток и не мучиться с настойками трав и утомительным полосканием. Но для того, чтобы ускорить процесс выздоровления, стоит все же проделать все эти процедуры. Для полоскания горла используют как настои трав, так и препараты из аптеки. Хорошо зарекомендовали себя следующие:
- Хлоропирамин;
- Лоратадин;
- Клемастин;
Пробиотики помогут исправить возможные нарушения в желудочно-кишечном тракте, это такие препараты как Линакс, Хилак Форте и другие. Высокую температуру не всегда необходимо сбивать, до 38 градусов это вполне допустимые показатели. Но при более высокой температуре жаропонижающие препараты Ибупрофен, Нурофен, Парацетамол.

Для того, чтобы снять боль в горле, существуют таблетки для рассасывания:
- Лизобакт;
- Неоангин;
- Травесил;
Заменять полноценное лечение полосканиями нельзя, это только дополнительные средства.
У полосканий задача не только снять боль и першение, таким образом, вымываются гнойные скопления на миндалинах, обеззараживаются очаги инфекции, и не позволяют ей распространяться дальше. Хорошо снимают воспаление растворы на основе соды, эвкалипта, прополиса и фурацилина.
Травы и также применяют для полосканий. Это такие сборы как:
- подорожник;
- шалфей;
- ноготки;
- кора дуба;
- ромашка;
Для достижения стойкого и терапевтического эффекта полоскания следует проводить 15-20 раз за сутки. При этом важно чередовать средства, это позволит снизить шанс адаптации вируса к лекарственным препаратам.
При фолликулярной ангине нельзя продолжать вести обычный образ жизни, снимать симптомы и находиться «на ногах». Постельный режим не рекомендован, а обязателен. Больной не только наносит вред собственному здоровью, но еще и заражает окружающих. Ангина крайне заразна, нельзя подвергать других риску, лучше провести несколько дней в постели.
Больным прописывается употребление большого количества воды, чая, особенно с лимоном и медом. Чем чаще пить отвары и напитки, тем быстрее инфекция покинет организм.
Питание также играет немаловажную роль в процессе выздоровления. Витамины и микроэлементы, которые присутствуют в сбалансированном меню, помогут организму побороть инфекцию. Вся пища должна подаваться в теплом виде, следует исключить грубую и острую.

В доме, где находится заболевший, проводится регулярная влажная уборка, проветривается помещение, но не допускаются сквозняки. Больной пользуется только личной посудой во избежание заражения окружающих бактериями. В течение нескольких дней симптомы стихают, а при грамотном подходе к терапии за 8 дней все проявления болезни исчезнут.
Общие рекомендации
Осложнения могут возникнуть как у детей, так и у взрослых. Тогда станет сложнее исправить ситуацию, и рецидивы болезни будут возникать постоянно. Так как только врач может отличить признаки ОРЗ от ангины, то посещение, и при необходимости бактериологическое обследование обязательно. Такие исследования проводят только со взрослыми пациентами. Для детей, если признаки заболевания очевидны, и имеют тенденцию к ухудшению, лучше соглашаться на госпитализацию.
Нельзя выработать общую для всех единую схему. Крайне опасно лечение фолликулярной ангины у взрослых антибиотиками или другими средствами, эта процедура проходит не легко. Есть такие препараты, которые только через пару дней начинают действовать на инфекцию. Помимо болезнетворных, антибиотики уничтожают и те, без которых человек не может существовать. Именно поэтому осмотр врача так важен. Самостоятельно никак не определить, что именно подходит для достижения результата.
Были проведены исследования, при которых несколько групп людей прибегали к различны способам лечения. Одни делали это при помощи антибиотиков, другие народными средствами, третьи антибиотики принимали, но не с первого дня. Выздоровление наступило у всех в одно и то же время, но те, кто использовал антибиотики, не пострадали от последствий болезни.
Все должно быть в меру, только сам человек больше всех отвечает за свое здоровье. И опасаться стоит, и пренебрегать антибиотиками нельзя, таковы основные рекомендации. Особенно осторожно следует подходить к лечению ребенка, так как он не способен принять верное решение.
prolegkie.com
Какими антибиотиками лечить фолликулярную ангину

Лечение фолликулярной ангины проводится такими же антибиотиками, какие используются и при борьбе с другими формами болезни. В первую очередь производится выбор из препаратов на основе пенициллинов, если они по каким-то причинам не подходят — выбираются антибиотики других групп:
- Цефалоспорины — по безопасности и эффективности они практически идентичны пенициллинам. В числе этих препаратов — Цефадроксил, Дурацеф, Супракс, Азаран, Апо-Цефалекс и другие;
- Макролиды, среди которых находится один из наиболее часто применяемых при ангине антибиотиков — эритромицин. К этой же группе относятся азитромицин, джозамицин, спиромицин и другие, из препаратов — Сумамед, Азитро-Сандоз, Хемомицин.

Хемомицин — один из препаратов на основе азитромицина
Линкозамиды — клиндамицин и линкомицин — назначаются редко. Эти антибиотики при фолликулярной ангине могут вызывать серьезные побочные эффекты, и потому их применение оправдано лишь в тех случаях, когда остальные препараты по тем или иным причинам назначать нельзя.
Для назначения действительно эффективного антибиотика при фолликулярной ангине врач должен знать:
- Какими бактериями вызвана ангина;
- Какие антибиотики больной принимал ранее, имелись ли у него аллергические реакции;
- Болел ли пациент ангинами в прошлом.
Как правило, тип возбудителя врач обычно не знает — выявление его требует не менее 3-4 дней, за которые ангину уже можно подавить антибиотиками широкого спектра действия. Поэтому выбирая, какой антибиотик надо назначить при фолликулярной ангине в конкретном случае, врач обычно учитывает вероятность аллергии и прописывает наиболее эффективный препарат, который будет активен и против стрептококка, и против стафилококка. Очевидно, что назначать себе антибиотик самостоятельно, без врача и учета собственной гиперчувствительности, опасно.

Стафилококк вызывает ангину реже, чем стрептококк, но он же обычно более устойчив к антибиотиками
Отзыв
«Один раз у нас на двоих детей была ангина. У Маши в четыре года фолликулярная. Врач прописал Сумамед, такой порошок с ложкой и мерным шприцом. Все удобно, применять легко, но больше всего меня удивил результат. Вот представьте: у ребенка ангина, воспаленное горло, гнойники на миндалинах, он плачет, температура. Мне реально страшно. Три раза в день пьет раствор порошка, на утро температуры нет, хочет есть, все прошло. Я была прямо удивлена. Хотя гнойники потом были ещё где-то неделю, но маленькая чувствовала себя хорошо.»
Оксана, Липецк
Пенициллины при фолликулярной ангине
Пенициллины — препараты первой линии выбора при фолликулярной ангине. Они достаточно безопасны (большинство пенициллинов можно применять под контролем врача при беременности и кормлении грудью), обладают отличными фармакокинетическими показателями (быстро всасываются в желудке, слабо расщепляются ферментами), редко вызывают побочные эффекты со стороны пищеварительного тракта. Если их применяет беременная женщина или кормящая мать, риск влияния на плод или грудного ребенка у этих антибиотиков минимален.

Чаще всего для лечения фолликулярной ангины назначаются лекарства на основе амоксициллина. По всем показателям этот антибиотик превосходит все аналоги, при этом препараты на его основе достаточно недороги и доступны.
Препараты на основе амоксициллина — это Флемоксин Солютаб, Амосин, Амоксикар, Амоксисар, Апо-Амокси, Оспамокс.
Другие антибиотики группы пенициллинов — это:
- Ампициллин — по фармакокинетическим свойствам значительно уступает амоксициллину. Часто применяется для инъекций во избежание расщепления значительно части в желудке. Препараты на его основе — Ампик, Апо-Ампи, Упсампи;
- Феноксиметилпенициллин — препараты Вепикомбин, Клеацил, Оспен.

Слабое место всех пенициллинов — появление большого количества штаммов возбудителей ангины, устойчивых к ним за счет выработки фермента пенициллиназы. Так, в большинстве случаев стафилококковой ангины возбудитель оказывается устойчивым к пенициллинам, а даже при стрептококковой инфекции все чаще пенициллинотерапия оказывается неэффективной из-за того, что вместе с возбудителем в тканях миндалин присутствуют бактерии, вырабатывающие пенициллиназу.
По этой причине в последнее время для лечения фолликулярной ангины все чаще применяют антибиотики на основе комплексов из ингибитор-защищенных пенициллинов. К таким комплексам относят:
- Смесь амоксициллина и клавулановой кислоты, входящая в состав средств Аугментин, Амоксиклав, Флемоклав-Солютаб;
- Смесь ампициллина и сульбактама (сультамициллин) — Амписид, Сультасин.
Такие антибиотики чаще оказываются эффективными, поскольку клавулановая кислота и сульбактам нейтрализуют защиту устойчивых бактерий к пенициллинам. Сегодня Аугментин и Амоксиклав при фолликулярной ангине считаются основными препаратами выбора для лечения болезни в домашних условиях. Они выпускаются практически во всех лекарственных формах и могут применяться и у взрослых, и у детей любого возраста.

3D-модель молекулы клавулановой кислоты
Все эти антибиотики — средства с высокой скоростью действия. Они позволяют уничтожить основное количество бактерий-возбудителей ангины за считанные часы. По данным исследований, в течение 12-24 часов после начала терапии этими средствами прекращается выделение стрептококковой микрофлоры из тканей миндалин. В основном эти лекарства назначаются в формах для перорального приема — в таблетках и капсулах для взрослых, а также в виде порошка и гранул для приготовления суспензии для детей. Инъекции этих антибиотиков считаются устаревшим методом лечения, которого в большинстве случаев можно избежать.
В некоторых случаях при ангине назначаются бициллины — средства на основе солей бензилпенициллина. Их главная особенность — длительное действие после введения в организм. У большинства больных препараты сохраняются в крови спустя 2-3 недели после инъекции. Это позволяет эффективно бороться с ангиной даже в ситуациях, когда возможно только однократное введение лекарства.
Минус бициллинов, сильно ограничивающий их применение — невозможность приема вовнутрь: в желудке эти препараты полностью расщепляются. Вводить их можно только внутримышечно, и потому применение этих антибиотиков при фолликулярной ангине ограничено ситуациями, когда невозможно организованное методическое лечение средствами для приема вовнутрь. Кроме того, бициллины часто применяются после основного лечения другими антибиотиками для профилактики осложнений ангины — они надолго предотвращают воздействие на организм продуктов остатков стрептококковой микрофлоры.
Препараты этой группы — Бициллин-1, Бициллин-3, Бициллин-5, Ретарпен, Экстенциллин.

Ретарпен — препарат из группы бициллинов, обладающий пролонгированным действием
Цефалоспорины: когда применяются эти антибиотики?
Антибиотики группы цефалоспоринов применяются для лечения фолликулярной ангины в таких ситуациях:
- Возбудитель болезни устойчив к пенициллинам, но не имеет резистентности к β-лактамам вообще;
- У больного имеется аллергия на пенициллины.
Наиболее часто применяемый при фолликулярной ангине антибиотик этой группы — цефадроксил. Тем не менее, в последнее время на рынке появилось множество лекарств на основе других цефалоспоринов — Супракс на основе цефиксима, Экоцефрон на основе цефалексина, Мефоксин на основе цефокситина. В частности, высокая эффективность Супракса при лечении фолликулярной ангины доказана многочисленными случаями результативного лечения. Причем в большинстве случаев Супракс оказывается эффективным в случаях борьбы с возбудителями, устойчивыми к пенициллинам. Однако, препарат не эффективен против ангин, вызванных стафилококковой инфекцией.

Супракс — препарат на основе цефиксима
Макролиды при фолликулярной ангине
Из макролидов при фолликулярной ангине чаще всего назначаются два антибиотика:
- Эритромицин, в том числе препараты Адимицин, Эрик, Грюнамицин;
- Азитромицин. Эффективен в том числе против бактерий, устойчивых к эритромицину.
Минусы этих средств заключаются в том, что они чаще пенициллинов и цефалоспоринов вызывают побочные эффекты со стороны пищеварительного тракта. Причем в некоторых случаях эти побочные эффекты могут быть более тяжелыми, чем сама фолликулярная ангина. Сумамед и Азитро Сандоз назначаются в том числе детям с возраста 1 года и выпускаются в виде порошков для приготовления суспензии, что обуславливает их широкое применение в педиатрии.

Азитро Сандоз в виде порошка, удобного для приема детьми 1-2-летнего возраста
Отзыв
«Диагноз прошлый раз — фолликулярная ангина, предположительно стрептококковая. Врач назначил Сумамед. Я просила что-то из пенициллинов, но он сказал, что в городе слишком много случаев устойчивости ангин к пенициллинам, и потому разумнее пить макролиды. Пила со страхом, боялась желудок посадить. Но ничего, пронесло. Вернее, не пронесло) Вообще будто этого Сумамеда не почувствовала, даже ухудшения аппетита не было. А так лечение было, как и сейчас — на второй день я уже себя хорошо чувствовала, остальную неделю допивала, потому что доктор сказал. Так что в целом можете пить его, достаточно безопасное средство.»
Таня, из комментариев

Какими антибиотиками лечится фолликулярная ангина у детей?
У детей при фолликулярной ангине назначаются те же антибиотики, что и у взрослых. Практически все популярные средства разрешены к приему с первых шести месяцев жизни. Учитывая то, что ранее ангина практически никогда не возникает (миндалины начинают развиваться только в три месяца, и в первый год жизни ангина у них — редкое явление), применять у них можно любые средства, выпускаемые в подходящей форме. Среди таких лекарств:
- Сумамед;
- Зетамакс Ретард;
- Азитро Сандоз;
- Амоксиклав;
- Аугментин…
…и другие. Для детей подходят антибиотики в форме порошка и гранул для приготовления суспензий.
Детям же часто назначают уколы бициллинов в целях профилактики поражения сердечной мышцы и развития других осложнений.
Видео: Как врач выбирает антибиотики при ангине?
Когда ещё назначают уколы антибиотиков при фолликулярной ангине?
Инъекции с антибиотиками при фолликулярной ангине могут быть необходимы в таких случаях:
- Пациент оказывается выполнять распоряжения врача — это может происходить в исправительных учреждениях, психиатрических больницах;
- Больной находится без сознания;
- Проявления ангины настолько сильны, что пациент не может проглотить таблетку или раствор;
- При отсутствии под рукой средств в других формах.
Как правило, почти во всех остальных случаях при фолликулярной ангине антибиотики можно принимать вовнутрь. Если врач назначает непременно уколы, имеет смысл поинтересоваться у него, с чем это связано — никаких преимуществ сегодня инъекции перед пероральным введением не имеют, но при этой у детей могут вызвать стойкую боязнь лечения.

Только в редких случаях антибиотики необходимо вводить внутримышечно
Порядок лечения фолликулярной ангины антибиотиками
Как правило, лечение фолликулярной ангины антибиотиками проходит в домашних условиях. Только в очень тяжелых случаях необходима госпитализация. Врач назначает конкретный препарат и указывает частоту его употребления и количество для каждого приема, а уже само лечение больной или его родственники организуют дома.
Любой антибиотик при фолликулярной ангине необходимо принимать не менее 7 дней подряд, иначе резко возрастает вероятность развития тяжелых осложнений. Обычно при болезни прописывается курс лечение на 10-12 дней, при слишком тяжелом течении — до 21 дня. Сокращать этот срок при нормализации состояния больного категорически запрещено — именно в ситуациях, когда больному кажется, что он уже здоров, антибиотик можно больше не пить, и он прекращает прием раньше срока, возникают поражения сердца и почек.
Каждый антибиотик в определенной форме в соответствии с его инструкцией принимается в определенное время с привязкой или без привязки к приему пищи.
На время острой фазы протекания болезни больному обеспечивается постельный режим с обязательным постоянным проветриванием помещения. На это же время ему назначается щадящая диета без острых, соленых и жареных блюд. Все продукты желательно измельчать и давать больному в виде пюре, чтобы не травмировать воспаленные миндалины.

Картофельное пюре — основное блюдо в острый период ангины
Больному ангиной вместе с приемом антибиотиков нужно очень много пить. Лучше обойтись простой чистой водой, при необходимости (особенно у детей) её можно заменять компотами, узварами, чаями — чем угодно, лишь бы больной получал максимум жидкости.
В качестве средств симптоматического лечения применяются:
- Жаропонижающие препараты — Нурофен, Парацетамол, Панадол — при повышении температуры выше 38°С;
- Средства для полоскания горла — отвары трав, солевой раствор, содовый раствор, различные специализированные смеси. Они обеспечивают очищение поверхности миндалин и некоторое ослабление болевого синдрома, но терапевтического действия не оказывают;
- Различные леденцы и таблетки для рассасывания с анальгетиками. Они применяются в основном для снижения боли.
Также при лечении фолликулярной ангины полезен прием различных мультивитаминных комплексов. Иммуномодуляторы, в том числе и средства на основе интерферона, однозначно при ангине не показаны. Решение об их приеме принимает врач на основе анализа состояния больного.

При улучшении состояния больного постельный режим можно отменять. Если ребенок или взрослый с ангиной имеет достаточно сил и желания для прогулки, с ним полезно выходить на улицу.
Важно!
При фолликулярной ангине нельзя кутать и согревать горло. Это приведет только к усилению инфекции и обострению симптомов. Также не рекомендуется при полосканиях слишком сильно беспокоить воспаленные ткани, чтобы не травмировать их и не усиливать боль.
Какими антибиотиками нельзя проводить лечение фолликулярной ангины?
Однозначно противопоказаны для лечения фолликулярной ангины такие антибиотики:
- Аминоликозиды — оказываемое ими токсическое действие может быть более сильным, чем проявления и последствия ангины;
- Левомицетины — по тем же причинам;

- Тетрациклины и сульфаниламиды — из-за высокой частоты резистентности к ним у возбудителей ангины и, как следствие, низкой эффективности препаратов;
- Антибиотики местного действия в составе леденцов или спреев. К препаратам таких антибиотиков относятся Грамицидин С, Граммидин Нео, Биопарокс и другие. Они неэффективны против возбудителя ангины и не позволяют эффективно бороться с инфекцией.

Граммидин — леденцы с антибиотиком тиротрициновой группы
Кроме того, в каждом конкретном случае для каждого конкретного пациента противопоказания могут иметь и обычные, применяемые в большинстве ситуаций, средства. Поэтому выбирать, какие антибиотики принимать при фолликулярной ангине, должен только врач, а уже лечение болезни почти всегда можно будет проводить дома.
Выводы:
- Для лечения фолликулярной ангины можно применять простые, доступные и безопасные антибиотики, применяемые при других формах болезни — пенициллины, эритромицин, цефалоспорины;
- Лечение фолликулярной ангины антибиотиками мало отличается от такового при лечении катаральной или лакунарной ангин;
- Назначение антибиотика должно проводиться с учетом возможной резистентности возбудителя к разным препаратам и гиперчувствительности самого больного. Прописывать средство должен только врач!
В продолжение темы:
Читайте также:
antiangina.ru
Какой антибиотик лучше при ангине?
Ангина, или тонзиллит – это инфекционное заболевание лимфатического глоточного кольца, в повседневной жизни называемого миндалиной. Располагаясь в области носоглотки и ротовой полости, этот элемент, являющийся скоплением лимфоидной ткани, выполняет различные кроветворные функции, а также оказывает защитные действия при вдыхании чужеродных патогенов. Возбудителем тонзиллита, являются инфекционные агенты в виде стрептококка и стафилококка, которые требуют специального медицинского реагирования. Какими антибиотиками лечить ангину, и какие существуют виды бактериального поражения глоточного кольца — вот о чем пойдёт речь в этой статье.
Видовая классификация и общая симптоматика тонзиллита
По типу развития воспалительного процесса тонзиллит делится на несколько видов:
- первичная или банальная ангина – клинические признаки воспаления присутствуют только при поражении лимфоаденоидного кольца носоглотки;
- вторичная, или симптоматическая ангина – это клиническое состояние возникает в результате обширного инфекционного поражения миндалин, с сопутствующими системными заболеваниями крови;
- ангина специфическая – этиология такой формы заболевания глоточных миндалин имеет особую диагностическую специфику.
Наиболее классическим и распространенным видом проявления ангины является банальная, или вульгарная форма, которая, в свою очередь, может классифицироваться на подвиды инфекционного поражения:
- катаральная;
- флегмонозная;
- фибринозная;
- фолликулярная;
- лакунарная и катаральная форма.

Общая симптоматика проявления ангины может проявляться в следующих признаках:
- недомогание и слабость организма, ломота в суставах;
- лимфатические узлы воспалены и заметно увеличены;
- температура тела достигает 40º С;
- боль при глотании и металлический привкус на языке;
- нёбные миндалины имеют ярко-красный оттенок;
- при некоторых формах тонзиллита образуются гнойнички или целые участки гнойного образования.
Первоначально вся симптоматика заболевания очень схожа на простудные болезни, однако, воспаление миндалин имеет более болезненное воздействие на весь организм человека. Очень важно вовремя диагностировать инфекционное поражение нёбных миндалин и определиться, какие антибиотики принимать при ангине. Следует отметить, что все фармакологические препараты следует принимать только после предварительного обследования у терапевта или участкового врача. Не нужно заниматься самостоятельным лечением, даже если вы однажды это делали успешно.
Катаральная ангина: лечение антибиотиками
При активном паразитировании на слизистой оболочке горла вирусных инфекций, вызывающих воспаление верхних дыхательных путей, возникает катаральная форма ангины, одна из самых лёгких и по течению заболевания, и по симптоматическим признакам. Перед тем как определиться, какие антибиотики пить при ангине такого типа следует пройти определенные медицинские процедуры. Очень важно, чтобы фармакологические препараты несли правильную информационную нагрузку на устранение самого инфекционного возбудителя при остром катаральном тонзиллите. Для этого и необходимо биохимическое обследование.

Существует целая группа фармакологических комбинаций при катаральной форме:
- Пенициллиновая группа. Действие этих медицинских средств направлено на блокировку метаболизма белков, входящих в клеточную бактериальную мембрану. Основной удар пенициллина – это воздействие на стрептококк.
- Для клеточного разрушения стенок бактерий используются цефалоспорины.
- Для подавления белкового синтеза используются препараты тетрациклиновой группы.
Исходя из клинических составляющих и индивидуального течения болезни, лечащий врач определяет, какой антибиотик лучше при ангине применить. Катаральная форма острого тонзиллита лечится по-разному у взрослых и детей, не говоря уже об особой категории граждан — беременных женщинах.
Фолликулярная ангина, какие антибиотики принимать?
Острый тонзиллит фолликулярного типа представляет собой гнойное воспаление миндалин, а точнее их фолликулов. Очаг гнойного поражения имеет точечный характер, и может затрагивать как нёбные участки, так и глоточно-язычковые. Антибиотики при гнойной ангине фолликулярного типа назначаются после дифференцированного лабораторного обследования, как то: взятие мазков из носа и зева для определения вероятного инфекционного возбудителя. После всех необходимых исследований, и при отсутствии аллергического отторжения, определяется, какой антибиотик при ангине наиболее эффективен. При лечении ангины такого типа используют фармакологические комбинации (антибиотики) первого и второго ряда:
- I ряд – это пенициллины — как ингибиторозащитные, так и полусинтетические. Курс эффективного лечения составляет не менее 10 дней. Амоксициллин, аугментин, экоклав, амоксиклав и пр. пенициллиновые группы используются во время лечения.
- II ряд – это макролиды, относящиеся к антибактериальной группе. Наиболее часто применимы: азитромицин, джозамицин и кларитромицин.

Каждый из этих фармакологических групп имеет своё строгое предназначение и воздействует на определенные клеточные структуры. Поэтому произвольный их выбор недопустим, и решение нужно оставлять за медицинским работником.
Лакунарная ангина: лечение антибиотиками
Какими же лекарственными средствами наиболее эффективно лечится такая форма острого тонзиллита? Всё коварство лакунарной ангины заключается в том, что в отличие от предыдущей, фолликулярной, где проявляются незначительные гнойные образования, этот вид ангины диагностируется при полном заполнении гноем элементов носоглотки. Так как главным возбудителем является бета-гемолитический стрептококк, при котором проявляется характерная сыпь на миндалинах и языке, то болезнь ещё носит название – скарлатина. Такие признаки инфекционного воспаления возникают у детей, заболевание является заразным и передается воздушно-капельным путём.
Симптомы лакунарной ангины у детей:
- Высокая температура тела, достигающая 39,5-40,5º С. Причём чем младше ребёнок, тем сильнее реакция и выше температура.
- Вялость, общая слабость, плаксивость, отсутствие аппетита.
- Жалобы на боль во время глотания.
- Першение в горле и ощущение присутствия постороннего предмета.
- Лимфатические узлы имеют сильно выраженное болезненное состояние.
- Понос, рвота, боль в животе (желудке), расстройство пищеварения.
Характерным и специфическим признаком является гнойный налёт на миндалинах малыша. На первых стадиях очаг воспаления имеет желтовато-бледный налёт на стенках.

Грамотная диагностика при своевременном обращении к врачу — это залог квалифицированного лечения и выздоровления ребёнка. Итак, лакунарная ангина, какими антибиотиками лечить заболевание? Прежде всего, из лекарственных фармакологических средств, при лечении выделяют антибактериальные препараты, имеющие широкий спектр действия. Дозировка и курс лечения определяется доктором, исходя из тяжести воспалительного процесса и возрастных критериев юного пациента.
В случае отсутствия аллергической реакции, эффективно проводить лечение ангины антибиотиками. Какими методами воздействия на стрептококки и стафилококки, будет руководствоваться лечащий врач, решать ему. В медицинской практике традиционно применяются пенициллиновые группы, макролиды, жаропонижающие и антигистаминные средства, а также пробиотики.
Фибринозная ангина
Такой воспалительный процесс нёбных миндалин происходит стремительно и всегда неожиданно, объединяя в себе все симптоматические признаки фолликулярного и лакунарного воспаления.
Симптоматика фиброзного воспаления:
- резкое повышение температуры, с пронизывающим ознобом;
- при болевом синдроме в горле, часто пациенты жалуются на отдающую боль в ухо;
- повышается интоксикация, влекущая за собой рвоту, тошноту, неприятие к любой пище, запахам еды и так далее.
Однако известны случаи в клинической практике, когда признаки фибринозной ангины никак не сказываются на общем самочувствии больного. При этом состояние слизистой оболочки у человека имеет удручающий, с точки зрения патогенеза, вид. Помимо вспомогательных мер воздействия, таких как прогревание и полоскание горла, необходимо пройти курс медикаментозного лечения. Фибринозная ангина, антибиотики, какие необходимо применять:
1. Амоксициллин – антибактериальный препарат пенициллиновой группы, обладающий специфическим действием на ферменты бактериальных клеточных мембран, что приводит к растворению и уничтожению вредоносно поврежденных инфекцией клеток.

2. Бензилпенициллин – обладает антибактериальным и бактерицидным действием, повышает уровень в крови, благодаря уменьшению почечной экскреции.
Назначая курс необходимой медикаментозной антибактериальной терапии, врач берёт на себя ответственность по качественному проведению лечения. Неправильная дозировка или неверно подобранная фармакологическая комбинация не только не убьёт инфекцию, но и сделает её более жизнестойкой. Высокая дозировка – опасна для жизни, а низкая – даёт надежду бактериям к антибиотической адаптации.
Флегмонозная ангина
Острый паратонзиллит, или флегмонозная форма ангины, является наиболее тяжёлым видом острого гнойного воспаления клетчатки миндалин. Болевой синдром при таком заболевании заставляет человека держать голову в вынужденном положении. Помимо всех симптоматических признаков свойственных острым гнойным проявлениям при ангине, флегмонозная форма проявляется в голосовой осиплости и/или гнусавости. Порою голос у человека практически пропадает, повышается слюноотделение, а запах изо рта вызывает дискомфорт у окружающих. Помимо этого, у больного может присутствовать контрактур нижней челюсти. Медикаментозная терапия в этом случае практически бесполезна. Эффективным методом лечения является только оперативная помощь хирурга.
Профилактика ангины у детей и взрослых
Прежде всего, следует помнить, что тонзиллит — это заболевание, вызванное инфекционным поражением бета-гемолитического стрептококка, который проявляет себя при слабой иммунной защите организма. Поэтому все усилия по предотвращению инфекционных поражений следует направить на укрепление своего организма.

Что для этого необходимо делать:
- Соблюдать правила личной гигиены: зубная щётка должна содержаться в чистоте; регулярное мытьё рук, особенно после туалета и перед приёмом пищи.
- Полноценное питание: основой рациона должна быть здоровая пища, основанная на растительных и минеральных компонентах.
- Психологическая устойчивость. Стрессовые ситуации вымывают из организма все питательные компоненты и нервная система не справляется с нештатными ситуациями.
- Физическая активность. Утренняя пробежка на свежем воздухе и лёгкие гимнастические упражнения станут прекрасным началом дня, обеспечивая заряд бодрости и жизненных сил на целый день. Замечено, что физически активные люди менее всего подвержены каким-либо инфекционным поражениям.
- Витаминная поддержка. Недостаток витаминов ослабляет защитные функции организма. Особо следует уделить своему здоровью в осенне-зимний период, когда все защитные функции организма естественным образом ослаблены. Комплекс витаминных компонентов группы А, B, C, и D в этот период значительно улучшит ваш жизненный тонус.

Для детей хорошей профилактической мерой станет закаливание. Контрастный душ во время принятия ванн повысит стойкость детского организма. Немаловажную роль играет и состояние ваших зубов. Кариес является рассадником различных инфекций. Проводя зубную профилактику у врача-стоматолога можно облегчить работу участковому терапевту.
Следите за собой и будете всегда здоровы!
antirodinka.ru
Какие применяют антибиотики при фолликулярной ангине

Фото: антибиотики при фолликулярной ангине.
Фолликулярная ангина — инфекционное поражение мягких тканей горла. Возбудителем заболевания являются два вида бактерий: стрептококк и стафилококк. Болезнь проявляется значительным увеличением температуры тела и образованием множественных фолликулов с гнойным содержанием.
При этом больной жалуется на затрудненное глотание и боль. Антибиотики при фолликулярной ангине считаются обязательным методом лечения, ведь только они напрямую воздействуют на причину воспаления.
Остальные способы терапии в виде полосканий, спреев и пастилок считаются дополнительными методиками лечения. Местное воздействие медикаментов на слизистую оболочку направлено на устранение отдельных симптомов болезни (боль, затрудненное глотание, отек). По мнению большинства врачей, стабилизация температуры и общего самочувствия больного происходит на второй день приема антибактериального средства.
Содержание статьи
Показания к антибиотикотерапии
Фолликулярная ангина и антибиотик считается абсолютно совместимыми понятиями. В таких случаях врачи склоняются к назначению антибактериальных препаратов широкого спектра действия. При этом если у пациента через 3 суток не наблюдается улучшение самочувствия и снижения температуры тела, то специалисты рекомендуют сменить медикаментозный препарат.
Противопоказания к антибиотикотерапии
Антибиотики при фолликулярной ангине не назначаются в таких случаях:
- Наличие у пациента аллергической реакции. Таким людям необходимо индивидуально подобрать антибиотик на основе аллергологических проб.
- Вирусная ангина. Этот диагноз устанавливает отоларинголог по результатам обследования больного. Зная, что такое фолликулярная ангина, специалист способен точно установить причину болезни.
Относительными противопоказаниями принято считать хроническую почечную и сердечно-сосудистую недостаточность.

Различия бактериальной и вирусной ангины
Общие правила проведения антибиотикотерапии
Назначение антибиотика осуществляется только врачом, который обследовал пациента и установил окончательный диагноз. Лечение начинается после определения индивидуальной переносимости антибактериального средства. В зависимости от клинической картины заболевания и возраста больного специалист может назначить фармсредство в виде уколов, таблеток или сиропа.
Антибиотики и фолликулярная ангина у детей имеют свои особенности. Врачи предпочитают назначать препараты в сиропе или суспензии. При этом дозировка препарата определяется в зависимости от веса ребенка или тяжести воспалительно-гнойного процесса, который весьма быстротечен.
По мнению многих отоларингологов самым эффективным видом антибиотикотерапии считается инъекция антибиотика. в таких случаях максимальная концентрация препарата в кровеносном русле наблюдается через 20-40 минут после укола. Средняя длительность терапевтического эффекта после одной инъекции составляет 4-6 часов.
Прием антибактериальных средств длится не менее семи дней. В противном случае при досрочном прекращении приема препарата у человека повторно развивается ангина фолликулярная, и антибиотики толерантны к инфекции. У таких пациентов патологическая микрофлора становиться полностью нечувствительна к воздействию конкретного вида антибактериального препарата.
Выбор фармсредства осуществляет только медик.
Какие антибактериальные средства применяются при фолликулярной ангине
В 90-95% случаев бактериальное поражение горла вызвано стафилококками и стрептококками. В связи с этим назначенный специалистом антибиотик при фолликулярной ангине должен активно уничтожать именно эти виды бактерий.
К основным антибактериальным препаратам относятся:
- Пенициллины (амоксициллин, ампициллин, аугментин, ампиокс). Эта группа препаратов была первыми открыта среди антибиотиков и используется с 1940-х годов. До сегодняшнего дня пенициллины считаются наиболее безопасным антибактериальным средством для человеческого организма. После внутреннего приема или инъекции они блокируют рост и размножение патологических микроорганизмов в дыхательной системе.
- Цефалоспорины (цефаспорин, цифран, цефтриаксон). Механизм действия цефалоспориновых антибиотиков идентичен пенициллинам. По сути, единственным отличием этих медикаментов является более широкий спектр воздействия на патологическую микрофлору носоглотки.
- Макролиды (азитромицин, суммамед и рулид). Особенность препаратов заключается в их способности к внутриклеточному накоплению в области воспалительно-гнойного процесса. Таким образом, значительно усиливается и расширяется лечебный эффект антибиотика. Данные антибиотики при ангине фолликулярной также облают противовоспалительным воздействием, которое не связано с уничтожением болезнетворных бактерий.
- Тетрациклины (макропен, тетрациклин, доксициклин). Данные фармсредства имеют широкий спектр действия, но в последнее время их применение ограничено. По статистике многие кокковые микроорганизмы устойчивы к тетрациклинам.
- Фторхинолоны (пефлоксацин, офлоксацин, спарфлоксацин). Терапия такими средствами в первую очередь направлена на борьбу с легочными осложнениями бактериальной инфекции. Это связано с тем, что фторхинолоны активно всасываются в ткани легких.Цена таких медикаментов, как правило, самая высокая.
Причины развития рецидива ангины после прохождения курса антибиотикотерапии
Отсутствие позитивного результата после приема пациентом курса антибиотиков связано со следующими факторами:
- Ошибочно поставлен диагноз бактериальной ангины. Что такое ангина фолликулярная и симптомы заболевания должен определять врач-отоларинголог.
- Резистентность организма человека. Патологическая микрофлора носоглотки оказывается абсолютно нечувствительна к действию конкретного вида антибиотика.
- Острое вирусное поражение тканей глотки и миндалин.
Основные осложнения антибактериального лечения
Стандартная инструкция к антибиотику описывает всевозможный побочные эффекты препарата.
Негативные последствия приема антибактериальных средств наблюдаются в таких формах:
- Аллергические реакции, которые могут иметь молниеносное или запоздалое течение. Наиболее опасным видом аллергии при этом является анафилактический шок, часто заканчивающийся летальным исходом.
- Токсическое воздействие на организм больного. Отравление человека в процессе антибиотикотерапии вызвано превышением допустимой дозировки или затрудненном выведением препарата. Такие пациенты зачастую страдают из-за патологического изменения функции нервной системы.
- Поражение почек. Это осложнение преимущественно формируется у людей с сопутствующей почечной недостаточностью. В таких случаях у больного обнаруживается белок и кровь в моче.
- Гепатотоксический эффект. Зачастую тетрациклиновые и хлортетрациклиновые антибиотики могут вызвать поражение клеток печени, что клинически проявляется желтухой. При отсутствии специфического лечения у пациентов развивается печеночная недостаточность, которая заканчивается смертельным исходом.
- Тератогенное действие. Многие антибактериальные препараты противопоказаны для приема беременными женщинами. Наибольшую опасность при этом имеет тетрациклин, который проникает через плаценту к плоду и может вызвать тяжелые нарушения развития ребенка.
- Расстройства работы желудочно-кишечного тракта. Большинство антибиотиков провоцируют воспаление слизистой оболочки ЖКТ. Такие пациенты жалуются на тошноту, боли в животе, диарею или запор.
Антибиотики при фолликулярной ангине являются обязательным методом лечения, но при этом требуют четкого соблюдения дозировки и длительности приема. Также следует помнить, что их использование регламентируют только лечащий врач.
gorlor.com


